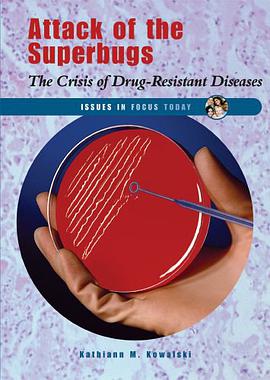
Attack of the Superbugs pdf epub mobi 电子书 下载

具体描述
书名:《光影交织的迷宫:一个城市边缘的观察者札记》 作者: 佚名 (A.N. Onymous) 页数: 480 页 装帧: 精装,附带独家历史照片和手绘地图集 出版日期: 2024 年秋季 --- 简介:在钢筋水泥的褶皱中寻找回响 《光影交织的迷宫:一个城市边缘的观察者札记》并非一部宏大的社会史,而是一份深嵌于日常纹理中的、对一个特定历史时期美国中西部大都市边缘地带的细致入微的考察报告。本书的作者,一位隐匿于公众视野之外的“观察者”,以一种近乎人类学家的严谨和小说家般敏锐的共情心,记录了自 1940 年代中期直至 1970 年代初期,在城市核心光环之外,那些被主流叙事遗忘的街区的生活实景。 本书的核心关注点在于“边缘化”本身所蕴含的复杂性、韧性与内在秩序。 观察者没有采用居高临下的批判视角,而是选择了一种“浸入式”的陪伴——他/她仿佛成为了那座由移民潮、经济变迁和种族隔离共同构建的“迷宫”中的一个影子,记录着光线如何被高耸的仓库和幽暗的弄堂切割、折射,最终投射到普通人的面孔上。 第一部:砖石与回声 (The Bricks and the Echoes) 本书的开篇,将读者带入了一个由密集的两层联排别墅和不断扩张的工业区共同界定的地理空间。作者以详尽的笔触描绘了这些社区的物理结构:那些漆面剥落的木制门廊、后院里由洗衣绳和杂物堆砌成的临时景观,以及在午后阳光下散发着热浪的柏油马路。 1. 社区的微观生态: 作者并未满足于描绘贫困的外观,而是深入挖掘了社区内部的社会运作机制。例如,书中详细记录了“邻里守望”系统的非正式运作,即那些依靠口碑和相互信任来维持治安和解决纠纷的民间结构。观察者细致地描摹了社区理发店、五分钱杂货店和地下室教堂如何充当了信息交换、情感庇护和文化传承的中心。 2. 工业的脉搏与消退: 紧邻居住区的庞大工厂,是这个社区的经济命脉,也是其命运的预兆。作者通过对清晨换班工人的描绘,展现了体力劳动者的尊严与疲惫。随着 60 年代末期产业结构的调整,书中捕捉到了第一波“白人外迁”(White Flight)和工厂裁员对社区士气造成的无声冲击,这种冲击并非爆发式的,而是像缓慢的地下水渗透一样,侵蚀着生活的根基。 第二部:语言的编织与身份的重塑 (The Weave of Tongues and Identity) 本书的引人入胜之处在于其对口头文化和非正式交流模式的捕捉。作者对不同世代、不同族裔群体之间语言的交汇与冲突进行了细致的文本记录。 1. “街角智慧”的存档: 作者花费大量篇幅记录了那些在街头、公园长椅上,或是在夏夜的消防栓旁流传的故事、谚语和俚语。这些口头传统,往往是抵抗主流文化霸权、自我赋权(Self-Affirmation)的有力工具。书中收录了许多未曾发表或被主流文献忽视的民间诗歌和即兴的“对白战”(Verbal Sparring),展现了语言的创造力。 2. 世代间的张力: 通过聚焦于家庭内部的沟通模式,作者揭示了战后移民一代与在本土长大的下一代之间在价值观、对外部世界的认知以及对“成功”定义上的巨大鸿沟。例如,老一代人对稳定工作的执着,与年轻一代渴望通过教育或艺术寻求突破的矛盾,被刻画得淋漓尽致。 3. 声音的政治学: 作者特别关注了社区中的声音景观——从布满裂缝的收音机里流出的爵士乐和福音歌曲,到汽车音响中被调到最大的 R&B 节奏,再到政治集会时扩音器里传来的、略带嘶哑的演讲声。这些声音共同构成了社区身份认同的背景音轨。 第三部:时间的碎片与未来的投影 (Fragments of Time and Projections of Tomorrow) 在本书的后半部分,观察者开始将视角投向 60 年代中期开始席卷全国的社会变革是如何渗透到这个相对保守的边缘地带的。 1. 间接的觉醒: 尽管这个社区并非社会运动的中心地带,但变革的影响是无处不在的。作者巧妙地捕捉了那些“间接”的觉醒时刻:比如,孩子们在学校里带回来的新的政治口号,街区教堂举办的关于民权议题的特别布道会,以及年轻人开始质疑家庭对职业规划的安排。这些变化是渐进的、带着犹疑和恐惧的。 2. 公共空间的再分配: 城市规划的“更新”项目,往往是外部力量对社区结构进行暴力干预的体现。本书记录了居民如何组织起来抵制某些拆迁计划,以及在某些情况下,他们不得不接受那些将他们彼此分割、将他们与市中心连接起来的全新高速公路的修建。作者将这些基础设施的变动,视为对社区社会资本的无形剥夺。 3. 观察者的退场与遗产: 最终,观察者以一种几乎是宿命般的清晰度,记录下自己离开这个社区的时间点。这种离开不是因为使命完成,而是因为观察本身已经成为了历史的一部分。本书的结尾,没有提供任何简单的结论或解决方案,而是留下了一系列未解的图像和深刻的疑问:在被历史遗忘的角落里,韧性是否能等同于胜利?生活在阴影下的人们,他们的日常史诗,将由谁来持续书写? --- 《光影交织的迷宫》 是一部对美国城市经历的“侧写”,它要求读者放下对宏大叙事的期待,转而关注那些在时间和结构重压下,依然努力维持自身完整性的个体生命。它是一份关于居住、忍耐、集体记忆和非正式文化力量的宝贵文献。本书的价值在于其无可替代的“在场感”,它让读者仿佛亲身经历了那个在历史的巨型阴影下,仍努力发出自己声音的社区的呼吸与心跳。 推荐读者: 城市社会学研究者、美国当代史爱好者、关注口述历史和非主流叙事的文学读者。
作者简介
目录信息
读后感
评分
评分
评分
评分
评分
用户评价
评分
评分
评分
评分
评分
相关图书
本站所有内容均为互联网搜索引擎提供的公开搜索信息,本站不存储任何数据与内容,任何内容与数据均与本站无关,如有需要请联系相关搜索引擎包括但不限于百度,google,bing,sogou 等
© 2026 book.quotespace.org All Rights Reserved. 小美书屋 版权所有